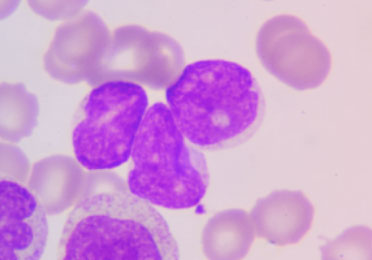
Histologische Aufnahme „Leukämiezellen“ zeigt mikroskopische Aufnahme von abnormen weißen Blutkörperchen.

Chronische myeloische Leukämie (CML)
URSACHEN, DIAGNOSE UND THERAPIEOPTIONEN
WAS IST EINE CHRONISCHE MYELOISCHE LEUKÄMIE (CML)?
Die CML ist eine bösartige Erkrankung der blutbildenden Zellen des Knochenmarks. Bei ihr vermehren sich Vorläuferzellen weißer Blutkörperchen (Leukozyten) unkontrolliert und sind somit im Übermaß in Blut und Knochenmark vorhanden. Das Besondere an der CML ist, dass die Ursache in einer ganz bestimmten genetischen Veränderung liegt. Dabei sind zwei Gene fälschlicherweise miteinander fusioniert. Eventuell sind Sie auch schon dem Begriff „Philadelphia-Chromosom“ begegnet. Bei diesem handelt es sich um das durch die Fusion von ABL und BCR stark verkürzte Chromosom 22.
Das so neu entstandene Fusionsgen produziert ein Eiweiß, eine Tyrosinkinase, das normalerweise nicht im Organismus vorkommt. Es ist sehr aktiv und greift in die Regulation des Zellwachstums und der Zellteilung ein. Der Körper kann diese Vorgänge nicht stoppen – unkontrolliertes Zellwachstum ist die Folge. Das Chromosom 22 kann in den meisten CML-Fällen mikroskopisch nachgewiesen werden. Im Bild unten sehen Sie, wie es zustande kommt.
SO ENTSTEHT DAS PHILADELPHIA-CHROMOSOM


Die positive Nachricht ist: Diese überaktive Tyrosinkinase kann sehr gezielt gehemmt werden. Die CML ist dadurch zwar nicht heilbar, aber das Zellwachstum kann so gut unter Kontrolle gehalten werden, dass ein chronischer Verlauf und ein Leben mit der Erkrankung möglich ist.
Übrigens: Die CML-auslösende Genveränderung wird im Laufe des Lebens erworben und ist somit nicht erblich. Was genau die Entartung der Blutstammzellen verursacht, bleibt meist unklar.
WIE HÄUFIG IST DIE CML?
Es erkranken jährlich 1 bis 2 Menschen von 100.000 an einer CML. Diese macht damit 13 Prozent aller Leukämiefälle aus. Dabei sind etwas mehr Männer als Frauen betroffen und die Häufigkeit steigt mit zunehmendem Alter. Das mittlere Erkrankungsalter liegt bei 55 bis 60 Jahren.
WIE MACHT SICH DIE CML BEMERKBAR?
Die Symptome der CML sind unspezifisch und treten meist schleichend erst im späteren Verlauf auf. Zu ihnen gehören unter anderem:
Die Weltgesundheitsorganisation (WHO) unterscheidet zwei Phasen der Erkrankung. Beide sind durch eine unterschiedlich stark ausgeprägte Symptomatik gekennzeichnet:
- In der chronischen Phase schreitet die Erkrankung nur langsam voran und ist meist beschwerdefrei.
- In der Blastenphase steigt die Zahl unreifer Vorläuferzellen, sogenannter Blastenzellen, im Knochenmark und Blut rasch an. Es kann zu einer Blastenkrise kommen. Die große Anzahl funktionsuntüchtiger Blastenzellen behindert die Bildung normaler Blutzellen. Der allgemeine Gesundheitszustand ist in dieser Phase zunehmend beeinträchtigt. Zudem kann es auch zu weiteren Gendefekten kommen.
WIE WIRD EINE CML DIAGNOSTIZIERT?
In Europa wird in 50 % der Fälle die CML zufällig entdeckt. Oft fällt hierbei zum Beispiel bei einer Routine-Blutuntersuchung eine hohe Zahl weißer Blutzellen auf.
Entscheidend für die Diagnose ist der Nachweis des Philadelphia-Chromosoms beziehungsweise der BCR-ABL-Fusion in Blut- und Knochenmarkzellen.
Mehr als 97 Prozent der CML-Fälle befinden sich zum Zeitpunkt der Diagnose in der chronischen Phase und sind somit gut therapierbar.
WELCHE THERAPIEOPTIONEN GIBT ES?
Zur Behandlung der Erkrankung stehen inzwischen verschiedene Therapieoptionen zu Verfügung:
- Tyrosinkinaseinhibitoren (TKI)
- Chemotherapie
- Interferon
- Allogene Stammzelltransplantation
- Teilnahme an klinischen Studien
Die Standardtherapie bei der CML sind Tyrosinkinaseinhibitoren (TKI), die das überaktive BCR-ABL-Fusionsprotein hemmen und so die Zellvermehrung stoppen. Mittlerweile stehen mehrere TKI mit unterschiedlichen Eigenschaften zur Verfügung. Eine mit mehr Nebenwirkungen verbundene Chemotherapie wird heutzutage allenfalls noch kurzfristig verabreicht. Etwa wenn eine sehr hohe Zahl weißer Blutkörperchen im Blut vor Beginn der TKI-Therapie zunächst zurückgedrängt werden muss.
Bei der Wahl einer für Sie geeigneten Therapie wird Ihre Ärztin oder Ihr Arzt folgende Fragen berücksichtigen:
- Welche Vorerkrankungen haben Sie?
- Wie ist das Nebenwirkungsspektrum der Therapie?
- Was sind Ihre Wünsche und Pläne?